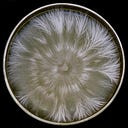

Kahikatea Walk at Peel Forest
After heavy rains over the Easter break, heaps of mushrooms popped up. This is what I spotted in a small section of Peel Forest.
Recent posts

Myconeer
Exploring fungal biodiversity one encounter at a time.
Recommendations
View all 9Aubrey Carter
The Microdose
Gillian Candler
Jess Jorgensen
Judson Carroll
Newsletters

As your guide, I bring you insights into the intricate world of close-up photography. You'll find comprehensive tutorials, detailed guides, and personal tips on everything from choosing the right gear to mastering the nuances of lighting and composition in macro shots.
This space is perfect for anyone eager to learn and seasoned photographers looking to enhance their macro skills. Join me and embark on a journey to capture the world's tiny wonders with spectacular clarity and detail!
Step into a mycelial exchange through this exclusive interview series. Each discussion brings insights into the world of mycology in an accessible and intriguing way. Join this exploratory journey as we uncover the fascinating interplay between fungi and our world, one conversation at a time.